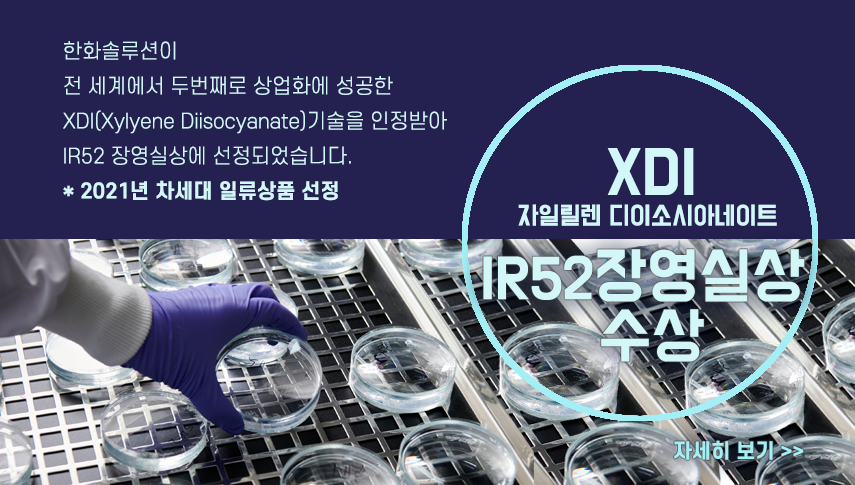

2022년도 얼마 남지 않은 지금,
올 한 해도 열심히 달려왔던 한화솔루션!
1년 동안 한화솔루션에겐 어떤 일들이 있었을까요?
2022년을 대표하는 주요 사업 소식들을 모아모아 전해드립니다!
하나, 가성소다, 연 100만톤 시대 연다
1월에는 한화솔루션이 3,380억 원을 투자해 여수공장 내 4만2900㎡(약 1만3000평) 부지에 CA 생산 설비를 증설하기로 한 소식을 전해드렸습니다.
전기자동차 시장이 급격하게 성장하고 있는 만큼, 2차 전지 및 전기차용 경량소재 제조에 꼭! 필요한 가성소다 생산을 늘리기 위해서죠.
둘, 초고압 케이블용 고부가 EBA 국산화
다음은 전량 수입에 의존해오던 초고압 케이블용 반도전 소재인 EBA를 한화솔루션이 국내 최.초.로 국산화에 성공했다는 소식입니다.
이 시장은 그간 해외업체들이 독점해왔는데요. 한화솔루션은 수 년간의 연구개발을 거친 끝에 자체 기술을 통한 국산화에 성공했죠.
셋, 폐어망 활용한 친환경 소재 공급
이제는 일상이 된 ESG! 한화솔루션이 빠질 수 없겠죠?
3월에는 한화솔루션의 100% 자회사 한화컴파운드가 폐어망을 활용한 친환경 소재 공급에 나섰다는 소식을 전해드렸습니다. 한화컴파운드는 삼성전자와 협업해 최신 플래그쉽 스마트폰인 '갤럭시S22 / 탭S 8 / 북 2 시리즈에 폐어망을 분쇄하여 가공한 친환경 폴리아미드(PA) 소재 부품을 공급하고 있습니다.
넷, 스타트업 '노보룹'과 업사이클링 기술 공동개발
6월에는 한화솔루션이 미국의 친환경 스타트업 노보룹(Novoloop)과 손 잡고 업사이클링 기술 공동개발에 참여했습니다.
전 세계적으로도 플라스틱 폐기물 문제가 심각해지고 있는 지금, 업사이클링을 통한 자원순환경제 구축을 위해 글로벌 파트너십을 체결했죠.
다섯, 한화솔루션-서울대학교 친환경 연구소 설립 협약체결
7월에는 한화솔루션이 서울대학교와 친환경 연구소 설립을 위한 협약을 체결했습니다.
대학의 최첨단 연구 지식과 기업의 기술 상용화 노하우를 결합해 다양한 친환경 솔루션을 개발하는 것이 목적인데요. 양 기관은 앞으로도 기후 위기 해결을 위하여 긴밀한 협력 관계를 이어갈 계획입니다.
여섯, 폐플라스틱 재활용한 친환경 화장품 용기 상용화
8월에는 한화솔루션이 한국콜마홀딩스, 화장품 용기 생산기업 연우와 손을 잡고 ‘친환경 화장품 용기 상용화’ 를 위한 업무협약을 체결했습니다.
화장품 용기는 일반적인 플라스틱 용기와는 달리, 다양한 소재가 사용되기 떄문에 재활용이 특히 어렵다는 사실! 이렇게 버려지는 폐기물을 줄이고, 환경오염을 해결하기 위해 한화솔루션이 나섰다는 소식입니다.
일곱, 초고압 케이블용 고부가 소재 EBA - 국가 신기술 인증 획득
9월에는 한화솔루션의 ‘EBA(Ethylene Butylacrylate Copolymer)를 적용한 초고압 전력케이블용 반도전 소재 제조 기술’이 신기술 인증을 받았습니다.
태양광, 풍력 발전을 통해 만들어진 전기를 송전하기 위해선 초고압 케이블이 반드시 필요한데요. 한화솔루션이 개발한 EBA는 우수한 내열성을 지니고 있어 초고압 전력케이블의 손상 방지에 쓰이고 있습니다. 전 세계적으로 재생에너지 발전의 중요성이 높아지고 있는 만큼, 관련 인프라 구축에 필수적인 소재라고 할 수 있죠.
한화솔루션은 연간 4만톤(t)의 EBA 생산 능력을 바탕으로, 국내를 넘어 해외 시장 점유율도 확대해 나갈 계획입니다.
여덟, XDI(자일렌 디이소시아네이트) - IR52 장영실상 수상
11월에는 한화솔루션이 전 세계에서 두번째로 상업화에 성공한 XDI(Xylyene Diisocyanate)기술이 IR52 장영실상에 선정되었습니다.
XDI기술은 높은 투명성과 굴절률을 자랑하고 있어 고굴절 안경 렌즈를 만드는 용도로 사용되고 있는데요. 그 외에도 투명성이 필요한 점·접착제, 코팅제, 실란트 등 다양한 분야에서 활용되고 있죠.
수입에 의존하던 XDI 기술을 한화솔루션이 자체 기술을 통해 국산화에 성공! (짝짝) 산업기술혁신에 앞장 선 국내 업체 및 기술 개발자들에게 주어지는 IR52 장영실상을 수상하게 됐죠.
* 2021년 차세대 일류상품 선정
아홉, Eco-DEHCH, CPVC, CP/TP 세계 일류 상품 선정
11월에는 한화솔루션이 개발한 프탈레이트 프리(Phthalate-free) 가소제 '에코데치(Eco-DEHCH)', '염소화 폴리염화비닐(CPV)', '코폴리머/터폴리머(CP/TP)' 등 3개 품목이 세계일류상품으로 선정되었습니다.
1. Eco-DEHCH(에코데치)
한화솔루션이 자체개발한 수소첨가기술을 통해 유해성분을 제거, 세계최초로 상업화에 성공한 소재입니다. 주로 벽지나 바닥재 등의 접착제로 사용되고 있습니다.
2. CPVC(염소화 폴리염화비닐)
염소화반응을 통해 일반 PVC보다 내열성을 강화한 소재로, 소방용 스프링쿨러, 온수배관 등에 사용됩니다.
3. CP/TP (코폴리머/터폴리머)
잉크, 접착제의 원료로 사용하는 고부가 특화 제품으로 한화솔루션은 연간 2.2만t의 생산능력을 보유하고 있습니다,
* 세계일류상품이란?
국산제품의 글로벌 시장선도와 수출활성화를 위해 산업통상자원부 주관으로 대한무역투자진흥공사가 운영하는 인증제도
열, 2022년 무역의 날 '20억불 수출의 탑' 수상
12월에는 한화솔루션이 ‘20억불 수출의 탑’을 수상했습니다!
케미칼 부문은 올해 21.3억불의 수출실적을 기록했는데요. 이를 통해 국가 무역발전에 기여한 공로를 인정 받아 20억불 수출의 탑을 거머쥐게 되었죠.
* 수출의 탑이란?
한 해 동안의 수출 실적을 바탕으로 국가 수출 경쟁력 향상과 산업발전에 기여한 기업에게 주어지는 상
올 한 해도 바쁘게 뛰어 온 한화솔루션!
2023년도 더 열심히 뛰겠습니다!
혁신을 향한 한화솔루션의 도전과 노력을 지켜봐주세요!





* 이 콘텐츠의 모든 저작권은 한화솔루션(주)에 있습니다.